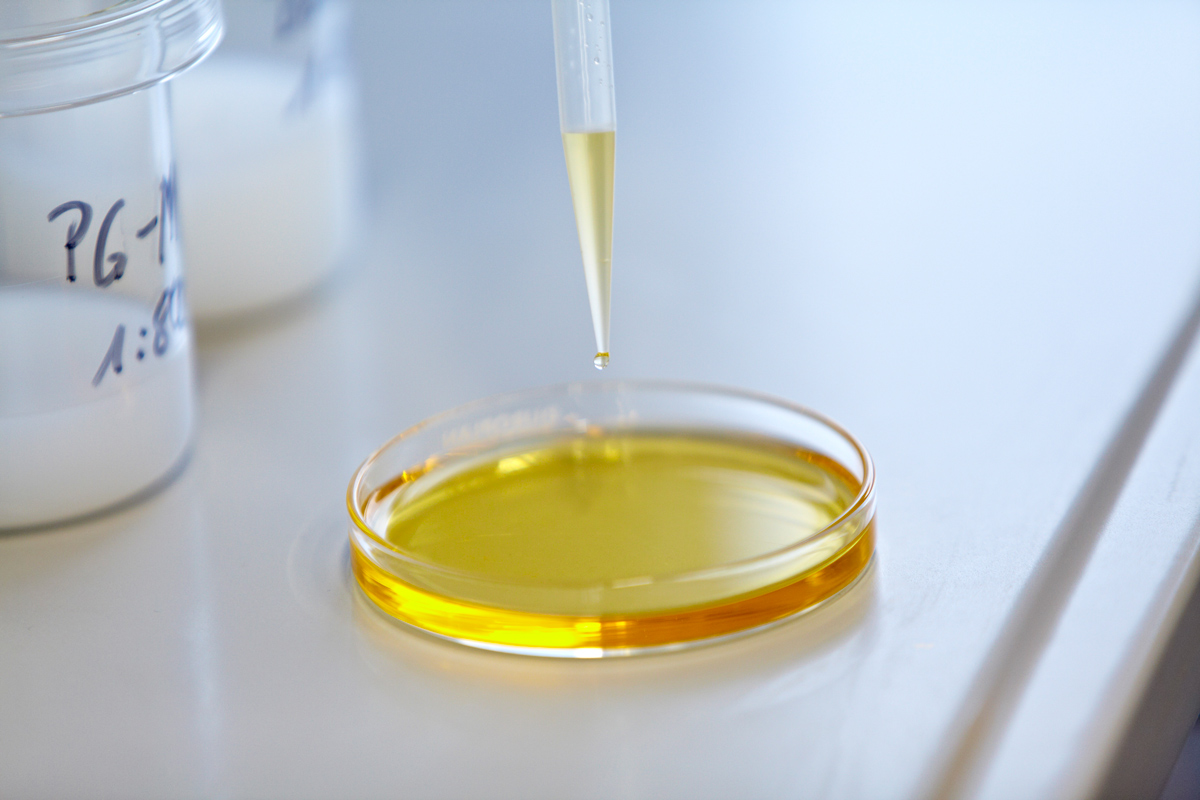

Services
PETROGUSS is ready to make visions of the customer come true. Therefore we always offer detailed analyses on site. Our products and supported processes are particularly environmentally friendly and have been complying with regulations for many years that will only have to be complied with in the future.
Environmental friendliness is very important to us. In addition, our solutions and special processes always enable significant improvements and thus contribute to increased productivity and lower costs.
The worldwide appreciated, high quality and innovative product range of PETROGUSS combined with the included service plus consulting often opens new horizons in the fields of foundry technology, industrial and cooling lubricants and/or industrial cleaners.